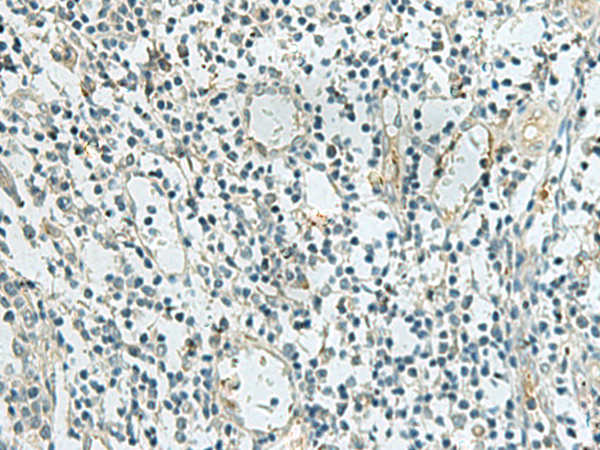

别名:RAPGAP; RAP1GA1; RAP1GAP1; RAP1GAPII应用:IHC
反应种属:Human, Mouse
规格:50μl/100μl
| Description |
|---|
| This gene encodes a type of GTPase-activating-protein (GAP) that down-regulates the activity of the ras-related RAP1 protein. RAP1 acts as a molecular switch by cycling between an inactive GDP-bound form and an active GTP-bound form. The product of this gene, RAP1GAP, promotes the hydrolysis of bound GTP and hence returns RAP1 to the inactive state whereas other proteins, guanine nucleotide exchange factors (GEFs), act as RAP1 activators by facilitating the conversion of RAP1 from the GDP- to the GTP-bound form. In general, ras subfamily proteins, such as RAP1, play key roles in receptor-linked signaling pathways that control cell growth and differentiation. RAP1 plays a role in diverse processes such as cell proliferation, adhesion, differentiation, and embryogenesis. Alternative splicing results in multiple transcript variants encoding distinct proteins. |
| Specification | |
|---|---|
| Aliases | RAPGAP; RAP1GA1; RAP1GAP1; RAP1GAPII |
| Swissprot | P47736 |
| Host/Isotype | Rabbit IgG |
| Storage | Store at 4°C short term. Aliquot and store at -20°C long term. Avoid freeze/thaw cycles. |
| Species Reactivity | Human, Mouse |
| Immunogen | Synthetic peptide of human RAP1GAP |
| Formulation | pH7.4 PBS, 0.05% NaN3, 40% Glycerol |
| Application | |
|---|---|
| IHC | 1/10-1/50 |
| ELISA | 1/5000-1/10000 |
![]() |
The image is immunohistochemistry of paraffin-embedded Human cervical cancer tissue using P13745(RAP1GAP Antibody) at dilution 1/20. (Original magnification: ×200) |
![]() |
The image is immunohistochemistry of paraffin-embedded Human tonsil tissue using P13745(RAP1GAP Antibody) at dilution 1/20. (Original magnification: ×200) |
本公司的所有产品仅用于科学研究或者工业应用等非医疗目的,不可用于人类或动物的临床诊断或治疗,非药用,非食用。
暂无评论
本公司的所有产品仅用于科学研究或者工业应用等非医疗目的,不可用于人类或动物的临床诊断或治疗,非药用,非食用。
中文

发表回复